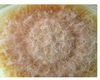

mycoplasma Flashcards
(20 cards)
discuss the preferable climatic conditions for aspergillosis
- it is a pre and post harvest contaminant
- prefers high temps
- tropical and subtropical climates
this mycoplasma prefers hot climates(tropical and subtropical)
aspergillosis
this mycoplasma is a storage mould
- pennicillin
- optimal growth = 16-28 degrees
- they are able to adapt to low pH environment (silage)
Most important phytopathogenic fungal genus
- fusarium
- Invasion and toxin formation on the living plant
mycoplasma which are Environmental „contaminants“:
in houses, stables, decaying material
- Rhizopus stolonifer
- Alternaria alternaria
what are the lesions of aspergillosis fumigatous in cattle
- omasum > rumen > reticulum
- necrohemorrhagic lesions, neutrophilia,thrombosis, pneumonia
- mycotic abortion
- mycotic mastitis
- Toxico-infections: Mould detectable in the tissues
a fungus that causes Respiratory diseases in horses
- A.fumigatous
- Hay and straw & indoor environment
- Fungal spores (A. fumigatus) & Recurrent Airway Obstruction (RAO)
the invisible moulds in grass and hay
Endophytes

list all the lesions/cs of ERGOTAMINE/Equine Fescue Toxicosis:
- abortion
- •prolonged gestation
- •premature separation of the chorionic membrane
- •thickened placenta
- •retained placenta
- •agalactia (suppression of lactation)
effects of ergotamine in cattle
- fescus foot
- heat intolerance
- very poor quality meat
this mycotoxin is an Inhibitor of Ca++-activated K+ channels.
lolitum B
when do u get to see cs in lolitrum B toxin
- > 1.2 ppm Lolitrem B visible clinical symptoms
- < 0.8 ppm no clinical symptoms
- cause staggers syndrome
- Lolitrem B concentrations
decrease during storage
5.6 → 0.9 ppm
(within 3 months) - Rate of degradation
depends on storage
conditions - Ataxia & Instability decrease within 48hrs after hay withdrawal
- Full recovery>6 weeks
- When diagnosed correctly,
Lolitrem intoxications
are completely reversible
DDx: Neuro-degerative diseases in horses
- Equine Herpes Virus Infections (EHV-1)
- Equine degenerative myelo-encephalopathy
- Polysaccharide storage myopathy
- Iliac thrombosis
- Equine motor neuron disease (EMND)
- Grass sickness (EGS)
Equine dysautonomia
Cl. botulinum type C
(Group III) Toxin ?
example of Endophytes in Legumes
Slaframine
cs of Slaframine
- Salivation
- Anorexia
- Diarrhea
- Loss of body condition
- characteristics of Fungal exotoxins
- Diverse chemical structures > 800 different toxins
- Low molecular weight haptens, non-immunogenic
- High lipophilicity high bioavailability (except: FB1)
- Physical stability heat resistance UV labileirradiation (environment: no item)
- (Bio)chemical stability pH-tolerance
- enzymatic degradation
- biotransformation
- glycosinolation (masked mycotoxins
- Biological function: increase in competitiveness
effects acute intoxication of mycotons in fish and chicken
Acute intoxications:
- Bile duct proliferation
- Fatty infiltration (pale livers)
- Reduced Vitamin A content
- Immunosuppression
cs of turkey x dz
- Weight loss
- Reduced feed conversion
- Anorexia
- Jaundice
- Depression
effects of ocratoxins
- Nephrotoxicity
- Polydipsia / Polyuria
- Growth retardation
- Hypothermia
- Immuunsuppression
- (Teratogenicity ?)
- Humans: Balkan endemic nephropathy
and UTT
up to page 23


